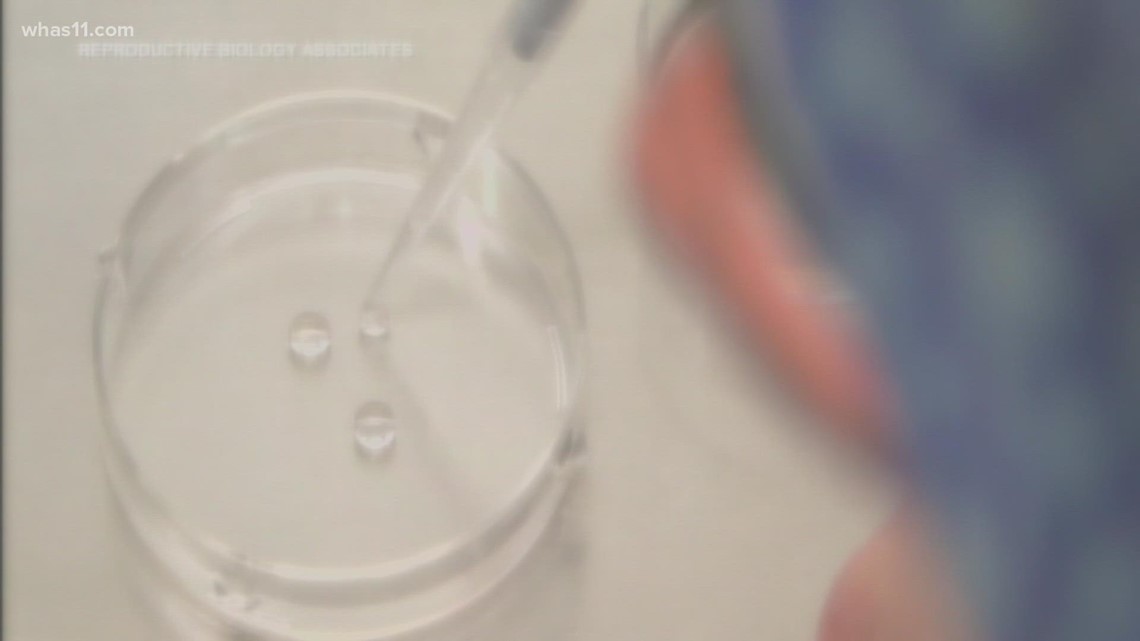

She loves to play with warm sperm on camera

ππ»ππ»ππ» FOR MORE INFORMATION, CLICK HERE ππ»ππ»ππ»
Lele Pons Cameltoe
Innocent Looking Porn Stars
Incest Porno Sex Hd
Bbw Brunette Anal Porn
Pussy Eating Girls
Jennifer Love Hewitt Fake Nude Pics
Double Creampie Guys Cum Inside Her 3
She loves to play with warm sperm on camera
smart\u0026width\u003d1200\u0026height\u003d675\u0026upscale\u003dtrue">

/cdn.vox-cdn.com/uploads/chorus_asset/file/13216253/private_life.jpg)





h_1853">c_limit/211122_a25822.jpg">





















0.00326xh\u0026resize\u003d640:*">

/cdn.vox-cdn.com/uploads/chorus_asset/file/19822301/curb_rankings_redux.jpg)

h_2182">c_limit/211122_a23481.jpg">




1200\u0026w\u003d450">


top\u0026resize\u003d480:*">







h_2400">c_limit/Bakchannel_Tosca-Musk-Passionflix-001.jpg">

/cdn.vox-cdn.com/uploads/chorus_asset/file/10726401/acastro_170817_1777_0001_v3.0.jpg)





